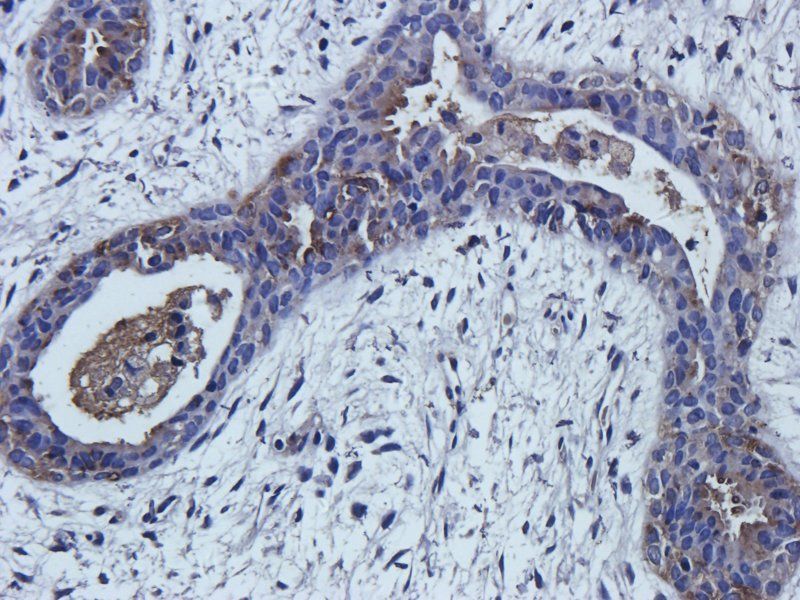
产品细节图片1
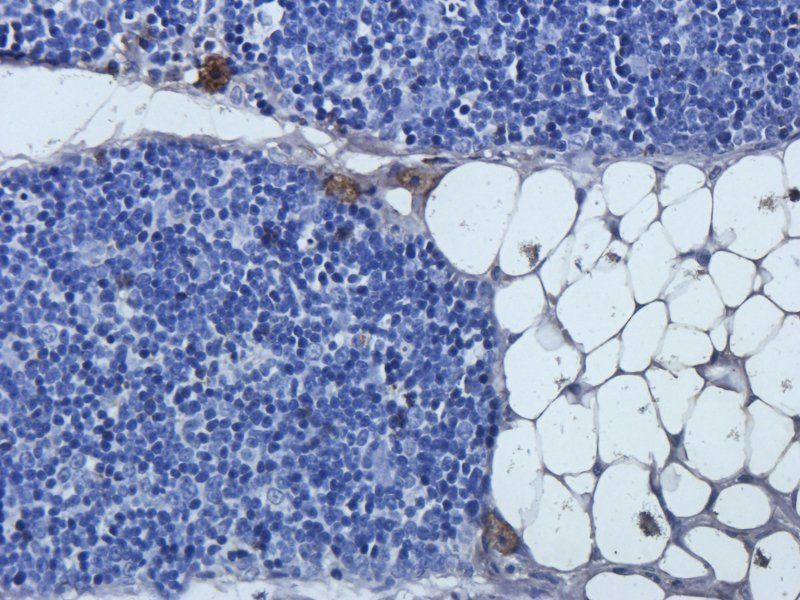
产品细节图片4
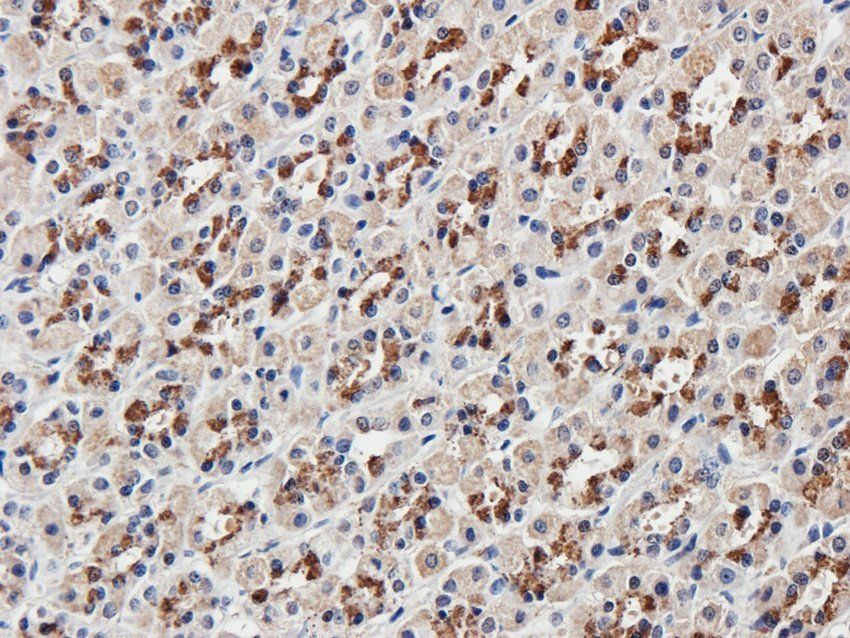
产品细节图片7

相关产品推荐更多 >
万千商家帮你免费找货
0 人在求购买到急需产品
- 详细信息
- 文献和实验
- 技术资料
- 抗体名:
Mlkl antibody抗体
- 抗体英文名:
Mlkl antibody
- 靶点:
Mlkl
- 浓度:
- 100 μg (in 200 μl): 0.5 mg/ml- 200 μg (in 400 μl): 0.5 mg/ml
- 应用范围:
ICC, IF, IHC-P, WB
- 宿主:
Rabbit
- 保质期:
6-12个月
- 抗原来源:
详询
- 目录编号:
orb32399
- 级别:
科研级
- 库存:
88
- 供应商:
biorbyt
- 标记物:
Unconjugated
- 克隆性:
Polyclonal
- 形态:
10 mM PBS, 0.02% sodium azide
- 亚型:
IgG
- 免疫原:
KLH conjugated synthetic peptide derived from human Mlkl. Please contact us for the exact immunogen sequence. The peptide is available as orb374793.
- 规格:
100 ug
别名:anti-Mixed lineage kinase domain-like protein antibody, anti-Mlkl antibody
免疫原:KLH conjugated synthetic peptide derived from human Mlkl. Please contact us for the exact 免疫原 sequence. The peptide is available as orb374793.
分子量:54 kDa
应用稀释比例:WB: 1:200-2000, IHC-P: 1:100-500, IF/ICC: 1:100-500
纯度:Polyclonal antibodies are purified by peptide affinity chromatography
保存说明:Maintain refrigerated at 2-8°C for up to 2 weeks. For long term storage store at -20°C in small aliquots to prevent freeze-thaw cycles.
Pubmed:39052071, 38611943, 37329888, 34430820, 27756058, 30136227, 33247805, 29560122, 31754092, 31677207, 30742091, 32545631
NCBI:001135969, 001142497
Entrez:197259
UniProt ID:Q9D2Y4, Q8NB16, D3ZKP6
Note:For research use only.

风险提示:丁香通仅作为第三方平台,为商家信息发布提供平台空间。用户咨询产品时请注意保护个人信息及财产安全,合理判断,谨慎选购商品,商家和用户对交易行为负责。对于医疗器械类产品,请先查证核实企业经营资质和医疗器械产品注册证情况。
文献和实验3) 依赖性细胞死亡来介导中暑。 热应激通过热休克转录因子 1 (HSF1) 增加 ZBP1 的表达,并通过独立于核酸感应作用的机制激活 ZBP1。ZBP1、RIPK3 或混合谱系激酶域样 (MLKL) 和 caspase-8 的缺失降低了热应激诱导的循环衰竭、器官损伤和致死率。因此,ZBP1 似乎具有协调宿主对热应激反应的第二个功能。 临床上,中暑的特征是极度高热、全身炎症反应、循环衰竭、出血和凝血障碍,以及热相关细胞毒性、炎症和弥散性血管内凝血 (DIC) 之间复杂相互作用导致的多器官
®应用领域 Incucyte®应用方向 在此,我们甄选出五篇使用Incucyte®的高引CNS文章,详细介绍实时活细胞分析技术的典型应用。 1. Science:免疫细胞杀伤 应用领域:肿瘤学 视频来源:Han-Chuang Hsiue et al. Science 2021, 05, 371(6533) 约翰霍普金斯大学的Shibin Zhou等人[1]开发出一种靶向TP53突变基因的双特异性单链抗体H2-scDb。采用Incucyte®的NucLight
,4046 个蛋白质被定量。与对照组相比,CUMS 组在 1.5 倍变化 (> 1.50 或 差异蛋白验证:免疫荧光证实,与对照组相比,海马 CA1 和 DG 亚区的神经元损失显著。对 RIP3、MLKL 和 p-MLKL 及与铁稳态失调和脂质过氧化相关指标,包括 Ftl1、MDA、GSH 和 GPX4 等进行 WB 验证,结果表明铁死亡和坏死与慢性应激诱导的抑郁有关。 6.2、IF 3-5 分文章:蛋白质组学+代谢组学 蛋白质组学和代谢组学检测 分析差异蛋白,对差异蛋白进行











